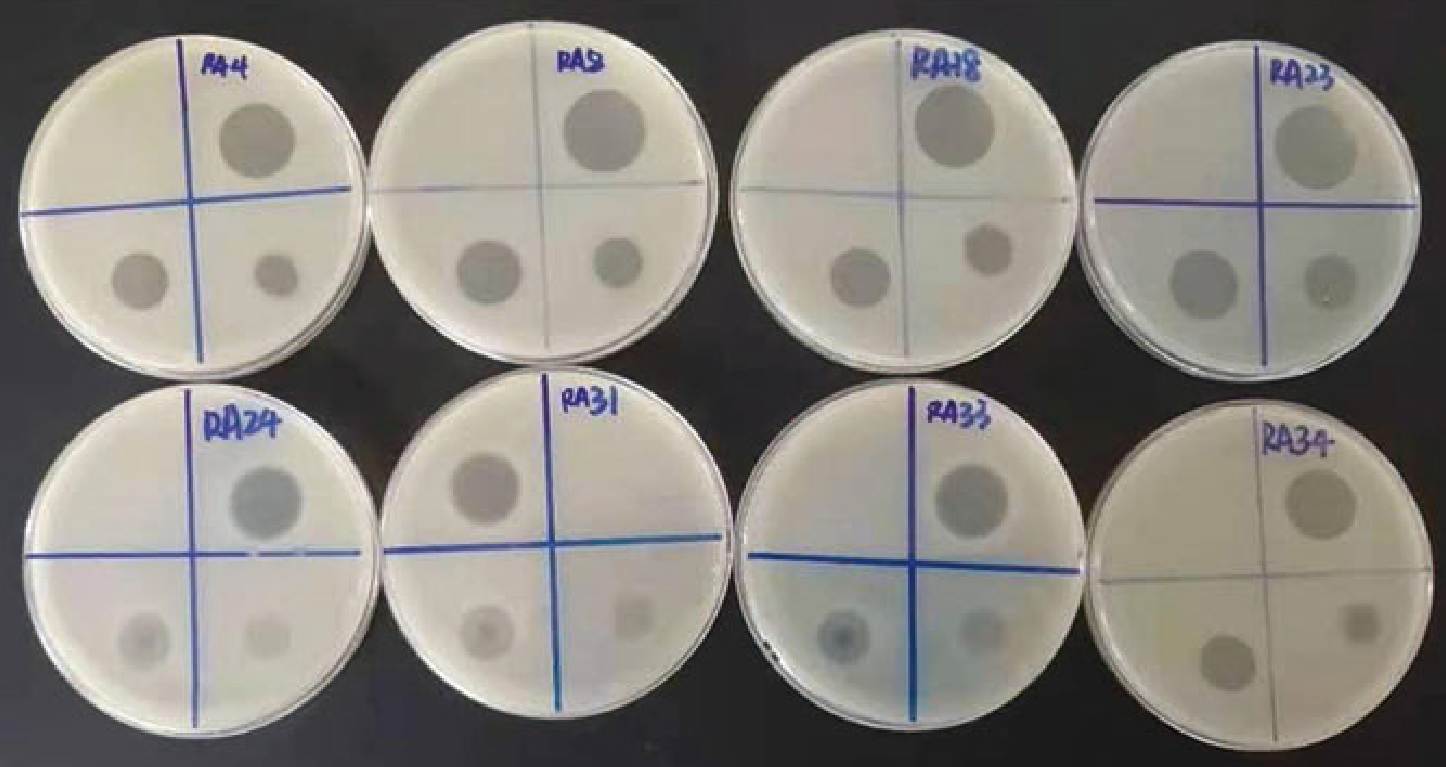
caadb235-8d26-4489-8c2b-9576f3f3a349.png

详情介绍
产品特点
1. 9株鸭疫里氏杆菌和8株大肠杆菌噬菌体混合物混合物
2. 噬菌体效价≥500亿pfu/L
3. 盲测裂解率高达98%
4. 有效治疗和预防水禽浆膜炎;
应用简介
1. 实验室验证
对分离自全国332株鸭疫里氏杆菌进行裂解,裂解率为98%
图1 鸭益宁对鸭疫里氏杆菌裂解效果
2. 实验室攻毒验证
60只10日龄雏鸭分为3组,各组如下处理
空白组:肌肉注射0.2mL生理盐水后正常饲喂;
攻 毒 组:肌肉注射0.2mL鸭疫里氏杆菌(GRN RA033,1x10'cfu/mL)后正常饲喂;
鸭益宁组:肌肉注射0.2mL鸭疫里氏杆菌(GRNRA033,1x10'cfu/mL)24h后,鸭益宁1:1000集中饮水治疗4天。

结论:鸭益宁对于鸭疫里氏杆菌有良好的抗菌作用,可有效促进机体恢复,对雏鸭浆膜炎治愈率高
3. 临床应用验证
鸭益宁对浆膜炎预防效果验证(WS公司)
| 组别 | 养户 | 存栏量 (羽) | 28日龄软脚数 (羽) | 发病率 (%) | 健活率 (%) |
| 鸭益宁 | 林 × | 6720 | 242 | 3.6 | 96.4 |
| 曾×× | 10380 | 200 | 1.9 | 98.1 | |
| 梁×× | 7800 | 98 | 1.3 | 98.7 | |
| 小计 | 24900 | 450 | 2.2 | 97.8 | |
| 抗生素 | 吴×× | 14640 | 1175 | 8.0 | 92.0 |
| 陈×× | 7500 | 768 | 10.2 | 89.8 | |
| 凌×× | 13080 | 1423 | 10.9 | 89.1 | |
| 小计 | 35220 | 3366 | 9.6 | 90.4 |
结论:1.鸭益宁可有效预防水禽浆膜炎
2.鸭益宁对浆膜炎的预防效果优于抗生素。
欢迎您的留言咨询
我们的工作人员将会尽快联系您,如果需要其他服务,欢迎拨打服务热线:027-87807288









